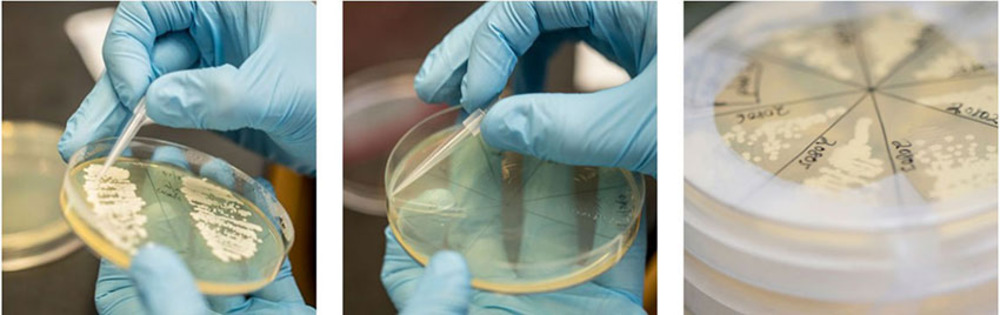
Search result

The University of Washington is known for its strategic, multidisciplinary research. Within our extensive network of Centers and Institutes, UW researchers, staff, and students work across disciplines to extend the boundaries of knowledge. For information on establishing a center, adding or making a change to a center listing, and other information for UW Center Directors, please visit our Centers Administration page.
KEMi is an $83M philanthropic contribution establishing a joint institute between the College of Engineering and UW Medicine to promote collaborations between clinicians and engineers to transform the future of health and healthcare.